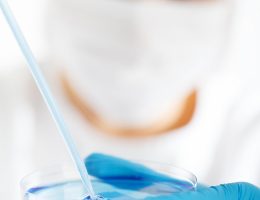
entdecken sie die faszinierende welt der wissenschaft. von den neuesten entdeckungen in der forschung bis hin zu bahnbrechenden technologien – erfahren sie mehr über die grundlagen und anwendungen der naturwissenschaften. ideal für neugierige und wissensdurstige!

IN KÜRZE Ort: Foyer der Staatsoper, Hamburg Datum: 1. bis 23. Dezember Uhrzeit: 16:30 Uhr (sonntags um 12 Uhr) Veranstaltung: Literarisch-musikalischer Adventskalender Inhalte: Geschichten, Gedichte, Lieder Vortragende: Mitglieder des Opern-Ensembles, Philharmonisches Staatsorchester, weitere Gäste Eintritt: Frei, Spenden für Freunde alter Menschen e.V. erbeten Programm: Täglich auf Social-Media und im Blog veröffentlicht Der Adventskalender der Hamburgischen …